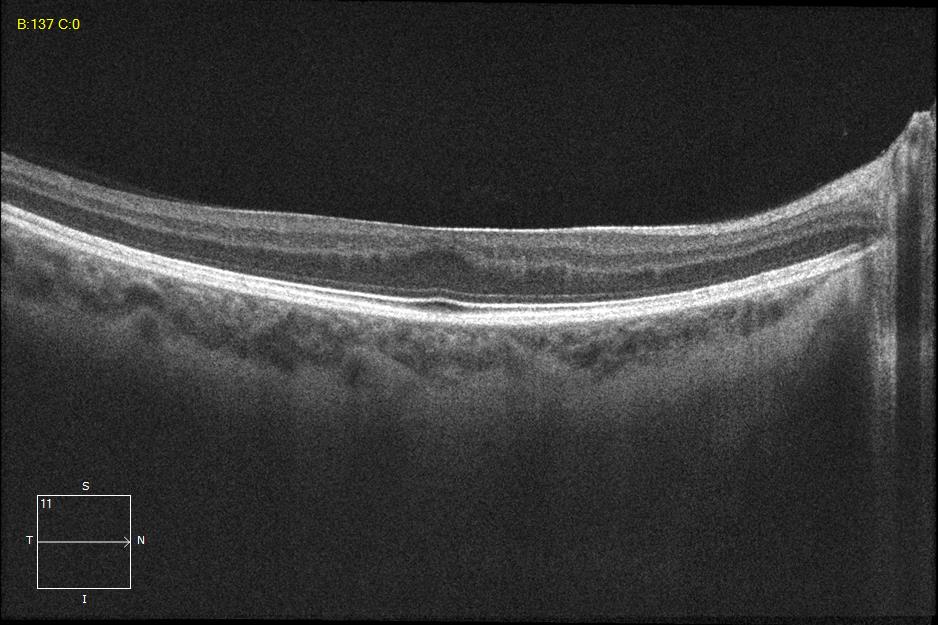
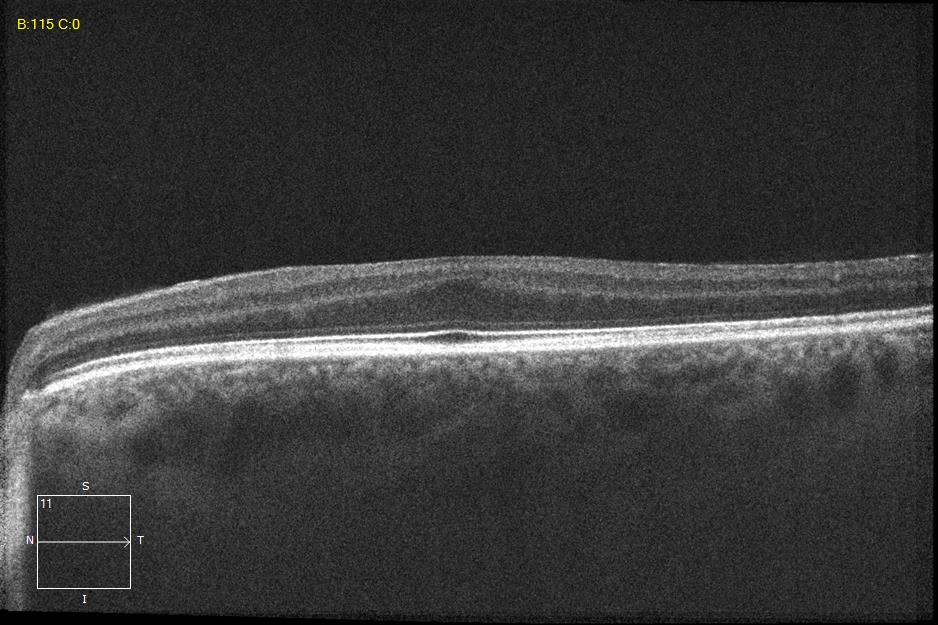
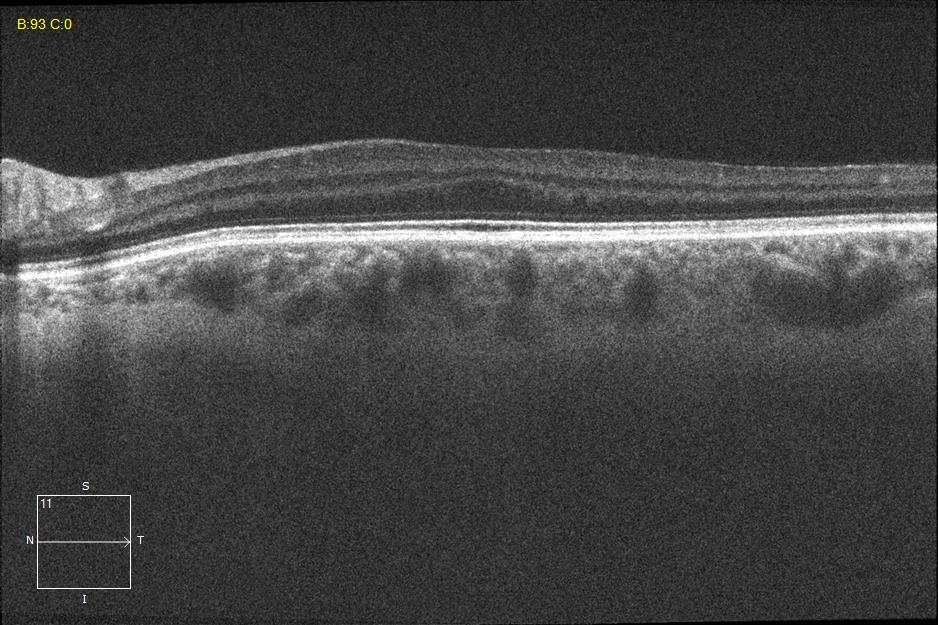
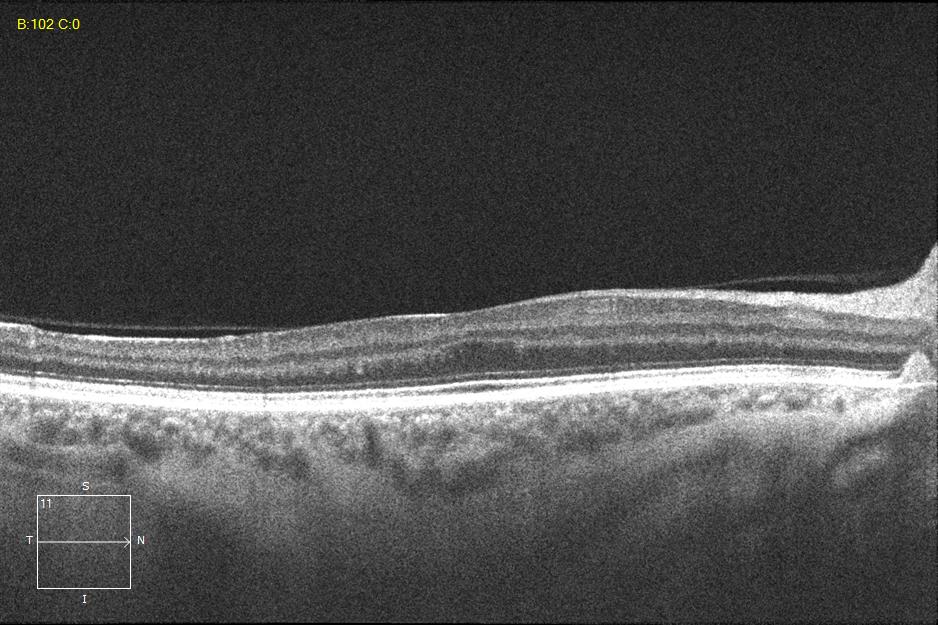

Two different patients with isolated foveal hypoplasia grade 2. The definitions of fovea plana and foveal hypoplasia have led to controversy among experts. The term fovea plane refers to the anatomical absence of a foveal pit. An estimated 3% of children with clinically normal eyes have an underdeveloped foveal pit on OCT. According to some experts, a foveal pit is not absolutely necessary for foveal cone specialization. A diagnosis of fovea plana alone does not automatically herald functional disability. It is possible to maintain adequate visual acuity in an eye with a fovea plana. Foveal hypoplasia refers to an underdeveloped fovea with vision loss. Foveal hypoplasia has also been seen in conditions such as aniridia, albinism, achromatopsia, nanophthalmus, and incontinence. pigment and premature retinopathy.
In contrast to other definitions, Thomas et al. defined foveal hypoplasia as the persistence of inner retinal layers in the fovea and developed a grading system based on optical coherence tomography features. According to this grading system, grades 2, 3, and 4 of foveal hypoplasia corresponded to the fovea plana.
Leicester Grading System for Foveal Hypoplasia;
Grade 1a foveal hypoplasia is associated with an almost normal pit resembling a “V” shape and outer segment (OS) elongation and outer nuclear layer (ONL) expansion relative to parafoveal OS and ONL lengths, respectively.
Grade 1b foveal hypoplasia is associated with a shallow indentation and OS prolongation and ONL widening relative to parafoveal OS and ONL lengths, respectively.
Grade 2 foveal hypoplasia has all the features of grade 1, except that there is no pit.
Grade 3 foveal hypoplasia represents all the features of grade 2 except that there is no lengthening of the OS segment.
Grade 4 foveal hypoplasia represents grade 3, except that ONL expansion is not present in the fovea (called the fovea plana).
Atypical foveal hypoplasia is characterized by distortion of the inner segment ellipsoid band, creating a shallow foveal pit and a hyporeflective zone.
Credit: M. Giray Ersoz, MD, FEBO
Biruni University School of Medicine, Department of Ophthalmology, Istanbul, Turkey
Instagram accounts: @retina.review and @retina.dr.girayersoz